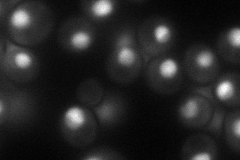
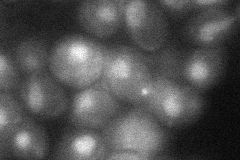
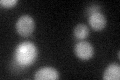
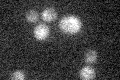

View description
TFIIF (Transcription Factor II) largest subunit; involved in both transcription initiation and elongation of RNA polymerase II; homologous to human RAP74
Localization:
Intensity:
Fold change:
Significance:
-
C’ GFP library in SD

below threshold15.74 -
N' NOP1pr-GFP in SD
nucleus77.0323 -
N' TEF2pr-mCherry in SD

nucleus98.8996 -
N' NATIVEpr-GFP in SD

nucleus29.7827 -
N' TEF2pr-VC and Cyto-VN in SD
nucleus33.6067 -
C’ GFP library in SD+DTT
cytosol17.281.09No -
C’ GFP library in SD+H2O2

cytosol19.471.23No -
C’ GFP library in Starvation Media
cytosol14.740.93No -
C’ GFP library on the background of Pup2-DaMP

below threshold -
C’ GFP library on the background of CCT mutant

below threshold17.55141.11442No
